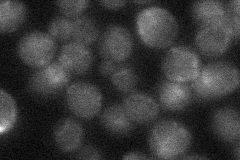
YNL080C
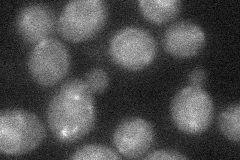
YNL080C

View description
Protein involved in N-glycosylation; deletion mutation confers sensitivity to exidative stress and shows synthetic lethality with mutations in the spindle checkpoint genes BUB3 and MAD1; YNL080C is not an essential gene
Localization:
Intensity:
Fold change:
Significance:
-
C’ GFP library in SD

below threshold16.5 -
N' NOP1pr-GFP in SD

ER51.9597 -
N' TEF2pr-mCherry in SD

ER63.7088 -
N' NATIVEpr-GFP in SD
punctate23.7042 -
N' TEF2pr-VC and Cyto-VN in SD
below threshold27.8782 -
C’ GFP library in SD+DTT

cytosol15.980.96No -
C’ GFP library in SD+H2O2

cytosol17.341.05No -
C’ GFP library in Starvation Media

cytosol24.351.47No -
C’ GFP library on the background of Pup2-DaMP

below threshold -
C’ GFP library on the background of CCT mutant

below threshold17.52761.06196No
